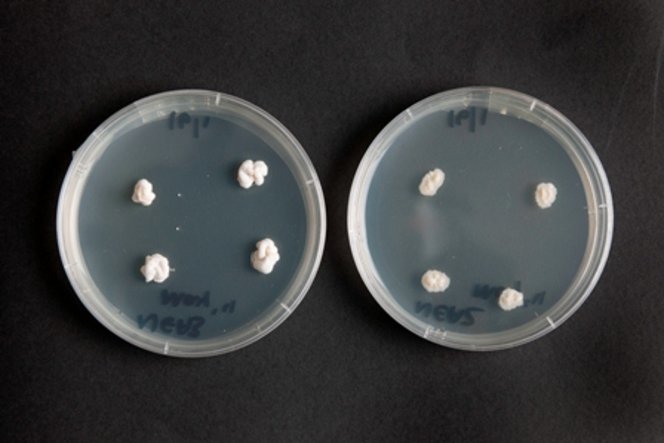

New Zealand
March 17, 2016
New Zealand’s top selling diploid and most widely used tetraploid perennial ryegrasses both contain NEA2 endophyte. Why is this? What makes it so successful?
You can’t divorce endophyte from its host ryegrass, and that’s a key reason NEA2 is working so well.
We have great cultivars with Trojan and Bealey, and a great endophyte with NEA2, but they also seem to combine really well.
This final point we think may be the key for their performance. Rather than breeding a ryegrass then putting a new endophyte in, as often happens nowadays, Trojan and Bealey naturally came with NEA2.
The result is the performance you get with Trojan NEA2 or Bealey NEA2, with a good spectrum of insect resistance. Most importantly for the upper North Island, they have three star ratings for black beetle control in the industry endophyte tables.
Trojan NEA2 provides a combination that really delivers in a great balance of performance and persistence that will suit a lot of different farm operations.
Bealey NEA2 is more specialised. While it’s more palatable – and Bealey is really special in this regard – tetraploids are less robust. They are more susceptible to overgrazing, treading and in a few cases ASW.
We have farmers using straight Bealey for over 10 years who love it, as do their stock! But they know how to treat it and give it TLC required to get the best out of it. Probably the most exciting innovation with NEA2 lately has been the Bealey:Trojan mix. We’ve tested a range of different mixes, and found that the Trojan helps ‘protect’ Bealey in the pasture.
The mixture of plants helps limit overgrazing to give a more robust pasture, while the inclusion of Bealey NEA2 improves animal intakes and makes grazing easier.And for the future we have our new tetraploid Viscount coming through adding extra performance.